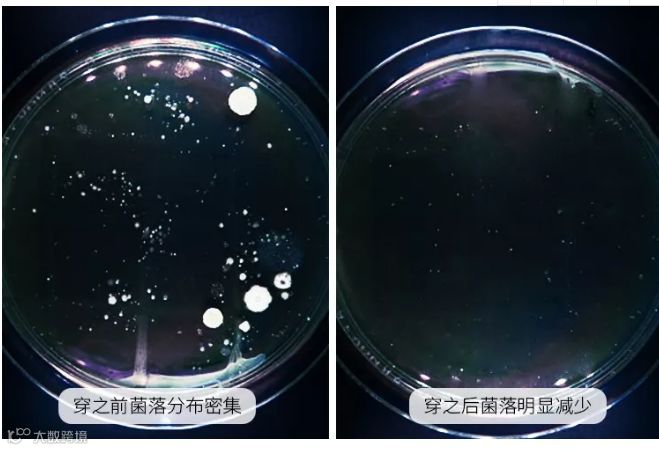

【通知】订阅号文末开启留言版块,大家希望上架的商品 留言备注到订阅号!
小编会统一反馈。

「下面就让我来详细介绍吧BI YANG」
集美优选
9点开抢!
·12345
【大牌团购】盼盼真虾脆片270g/袋 原价:89元 大牌团购价:29.9元 可以当抱枕的虾片你造吗?
盼盼真虾脆片,比脸还大!
好大一包虾片,
想想吃起来是不是太爽啦~
集美优选
12点开抢!
【大牌团购】MAC双效定妆喷雾100ml 原价:200元
大牌团购价:129元 女孩儿们的烦恼
大概是早上出门画个精致的妆
本来要美腻一天的~
结果晚上约会还没开始🔛
妆花了,啊~崩溃啊~
别沮丧,宝宝们~
给你们安利一个“神奇”
当当当当~
MAC魅可定妆喷雾
MAC畅销产品之一,定妆喷雾里面含有保湿的成分,化完妆喷一喷能够马上减轻粉感,加强皮肤的保湿,看上去有光泽的同时又能定妆,非常适合干皮的人使用
添加了天然胶原矿物质的喷雾泉水
以矿物质、多重花果萃取精华
以及丰富的维他命为主要成分
可以帮助皮肤锁住水分
从而延缓皮肤的出油力
另外里边含有活氧复合物、丙烯聚合物
可以有效形成皮肤保护膜
对抗出汗及外部污染
可以牢牢的定住脸上的妆容
而且不会有黏糊糊的感觉,使用感很可~
喷一喷持妆特别久,而且干皮都不怕用散粉粉饼会浮粉什么的了!
妆前妆后都ok,人瞬间清醒的感觉! 皮肤摸起来滑滑的,感觉炎炎夏日更不容易脱妆了!
这款不是普通的化妆水和补水喷雾呦~
既能妆前使用,又可以妆后定妆
关键是小小的一只带在身上非常方便
可以随时拿出来补妆
增加皮肤的水分,减少粉痕~
![]()
集美优选
14点开抢!
【大牌团购】天然乳胶内裤3条装 原价:59元 大牌团购价:39.9元 女性保护自己的第一步,就应该是从私处健康开始!
其实市面上那么多的布料材质,就数乳胶的效果是最好的,它有“螨虫克星”之称,能很好的抑菌防螨、保护生殖健康!
推荐给集美们这款天然乳胶内裤。
内裤裆部采用天然进口泰国乳胶,不掺一滴人工合成的丁苯橡胶,经过国家检测机构的权威检测,乳胶含量≥93%,抑菌防螨率升级,安心呵护娇嫩的肌肤~
因为乳胶中含的橡树蛋白,可以有效抑制螨虫和细菌滋生,即使排泄物渗透进乳胶底裆,私处也不会有细菌滋生,更别提会瘙痒了!
防螨抑菌,高弹性、透气性极佳的功能!
买过泰国乳胶枕头的人都知道,天然乳胶取自泰国橡胶树精心提炼出的汁液,被称为“树的眼泪”,是天然的抑菌除螨剂。
据研究结果显示,乳胶对大肠杆菌、金黄色葡萄球菌、白色念球菌等,常见细菌的抑制率是普通内裤的3~4倍!
乳胶内裤有极佳的透气性,无论是什么天气、穿着多厚的衣服,穿上它不会闷出汗或产生异味,更不会滋生细菌。
每天穿着乳胶内裤滑滑的很通透,超舒服!
这款乳胶内裤采用一片式热压无痕工艺,360度包裹臀部,安心不留一点痕迹!就算穿紧身的裤子走在街上也不怕尴尬。
而且还不卷边、不翘边,穿着就如同自己的第二层肌肤一般,让你尽享“裸穿”体验。
穿在身上舒服到好像没穿一样,乳胶内裤面料清爽柔软,乳胶底裆又透气排湿,感觉下体得到了解放、时时刻刻在呼吸新鲜空气~
【颜色】粉色灰色肤色
【规格】一盒/三条
【码数】均码
![]()
集美优选
19点开抢!
【大牌团购】泰国 Atreus/生姜洗发水400ml 原价:79元 大牌团购价:39.9元
市面上也有很多打着生姜增发的护发品,但产品质量难以保证,大多数只有生姜香料而已,用了再多也没有作用。 ![]()
![]()
而ATREUS生姜洗发水采用了蒸馏法提取生姜,百分百真材实料,100公斤=1公斤生姜提取物。 不像其他生姜产品辣得头皮疼,这个超温和,洗护一体。 ![]()
泰国ATREUS生姜洗发水
400ML,超大容量,高性价比
深入清洁头皮,滋养发心~
绝不添加硅油~
提取姜根提取物、椰油酰胺、柠檬酸、 小麦蛋白等纯天然植物成分加入, 给秀发带来十倍的呵护。
使用前后对比
清爽去屑,不伤发丝
强韧发丝,柔顺亮泽
优质产品,好评如潮
小红书口碑见证
![]()
集美优选
21点开抢!
【大牌团购】日本 YANAGIYA柳屋超爽快生发滋养液240ml*1瓶 原价:109元 大牌团购价:89元 秃头星人的最爱——柳屋生发液
正在掉发严重的朋友,都建议用它!混在洗发水里或单擦后按摩头皮都很好,使用感100分。含龙胆,人参,苦参及延命草的提取物,在日本家喻户晓!
在这个看脸的世界 除了脸,发型又帅又美也是关键 如果你头发稀少 再帅气、漂亮的脸蛋也要败下阵来 头发决定一个人的外在形态和气质 是决定颜值的一个必要装饰 拥有无可替代的作用
柳屋生发滋养液
育发,养发、脱发预防,
用量很省,能用很久
每天2~3次,适量滴出
用手指按摩头皮就好咯,
防脱-生发,效果立竿见影!
头发少就擦哪里,完全不油腻,
干了也不会油
不仅能舒缓头皮, 疏通毛孔刺激生发 还能控油止痒, 连续用几周能看到明显效果。
JOIN US
集美优选跨境购
约上小伙伴!
快来!
扫描二维码关注公众号
进入集美优选商城
了解更多产品信息
点个赞

再走吧

快来!